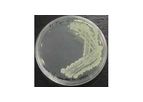
Culture Media for Labs

- Home
- Companies
Show results for
Refine by
Environmental Industry Research Institute
3 companies found

Research institutebased inIsnes, BELGIUM
Artechno, whose core business is the production of microbes pure cultures, was created in 1999 as a spin-off company stemming from research at the Walloon Center for Industrial Biology (CWBI – Belgium). This research institute on industrial biology ...
From its know-how in bacteria cultivation and in natural products, Artechno produces and distributes a range of culture media for microbe cultivation (bacteria, moulds, yeasts) or for cell cultivation. These media may serve for : water quality ...

Research institutebased inOslo, NORWAY
Aquateam COWI is a supplier of knowledge and research within the water and environmental sectors. It drives independent applied research as well as commercial oriented- research. Aquateam COWI has provided a link between universities/research ...
Aquateam operates its own, well equipped laboratory for use in all types of projects. Here, we install test-rigs, pilot installations and reactors to test processes in lab-scale for offshore-, industry and municipal customers. For stand-alone ...

Research institutebased inFarnham, UNITED KINGDOM
The Centre for Sustainable Design (CfSD) facilitates discussion and research on eco-design and environmental, economic, ethical and social (e3s) considerations in product and service development and design. This is achieved through training and ...
OpenGreen is a one day open innovation workshop aimed at identifying new income generating opportunities for more sustainable products, services and product-services. OpenGreen is powered by the GreenThink © process that has been developed by ...